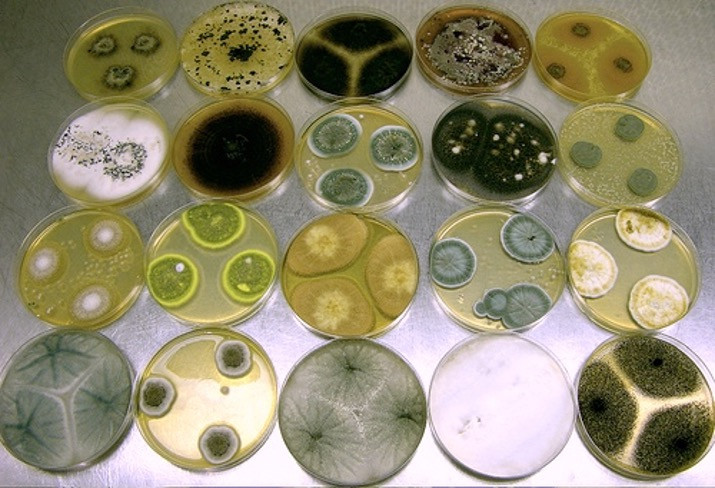

Avvisi e documenti utili del corso METODOLOGIE PER LA CONSERV. RESTAURO BENI CULTURALI
Codice insegnamento 61698
Ricevimento Roberto Cabella: Il ricevimento degli studenti avviene per appuntamento, concordato direttamente con il docente telefonicamente, per mail o via aulaweb
Inizio lezioni:
Consultare orario dettagliato al seguente link: https://easyacademy.unige.it/portalestudenti/
Corsi di laurea, sedi, programma, obiettivi, modalità d'esame e altre informazioni
- Docente: Roberto Cabella
Codice insegnamento 61701
Ricevimento Stefano Vanin: Contattare il docente via mail per definire una data di appuntamento: stefano.vanin@unige.it
Ricevimento Giorgio Bavestrello: Il ricevimento degli studenti sarà concordato direttamente con il docente.
Inizio lezioni: Consultare orario dettagliato al seguente link: https://easyacademy.unige.it/portalestudenti/
Si rimanda all'istanza AulaWeb specifica dell'insegnamento per eventuali aggiornamenti a causa di variazioni della situazione sanitaria ed epidemiologica.
Corsi di laurea, sedi, programma, obiettivi, modalità d'esame e altre informazioni
Modulo, vedi anche: BIOLOGIA APPLICATA ALLA DIAGNOSTICA E ALLA CONSERVAZIONE DEI BENI CULTURALI - 61699
- Docente: Giorgio Bavestrello
- Docente: Stefano Vanin
Codice insegnamento 101277
Ricevimento Simone Di Piazza: Concordato direttamente con il docente telefonicamente al numero 010 3538240 oppure tramite e-mail (simone.dipiazza@unige.it).
Inizio lezioni: Le lezioni si svolgeranno nel secondo semtre da aprile a giugno
Per l'orario dettagliato consultare il seguente link: https://easyacademy.unige.it/portalestudenti/
Corsi di laurea, sedi, programma, obiettivi, modalità d'esame e altre informazioni
Modulo, vedi anche: BIOLOGIA APPLICATA ALLA DIAGNOSTICA E ALLA CONSERVAZIONE DEI BENI CULTURALI - 61699
- Docente: Simone Di Piazza
Codice insegnamento 104557
Ricevimento Marco Salerno: Il docente della prima parte riceve su appuntamento nel suo studio, S713, a valletta Puggia;
può essere contattato tramite email a marco.salerno@unige.it.
Inizio lezioni: Per la prima parte (24 ore) data di inizio e calendario delle lezioni verranno resi noti a settembre 2025.
Corsi di laurea, sedi, programma, obiettivi, modalità d'esame e altre informazioni
- Docente: Michele Brancucci
- Docente: Marco Salerno
Codice insegnamento 108623
Ricevimento Paolo Piccardo: Gli studenti che vogliano incontrare i docenti sono invitati a prendere appuntamento tramite email: paolo.piccardo@unige.it
Inizio lezioni: Fine settembre in accordo con il calendario pianificato dal corso di laurea
Corsi di laurea, sedi, programma, obiettivi, modalità d'esame e altre informazioni
- Docente: Paolo Piccardo
Codice insegnamento 98859
Ricevimento Mirca Zotti: Concordato direttamente con il docente telefonicamente al numero 010 3538240 oppure tramite e-mail (mirca.zotti@unige.it).
Ricevimento Simone Di Piazza: Concordato direttamente con il docente telefonicamente al numero 010 3538240 oppure tramite e-mail (simone.dipiazza@unige.it).
Inizio lezioni: Le lezioni si terranno nel secondo semestre.
Vedere l'orario dettagliato al seguente link: https://easyacademy.unige.it/portalestudenti/
Corsi di laurea, sedi, programma, obiettivi, modalità d'esame e altre informazioni
- Docente: Simone Di Piazza
- Docente: Mirca Zotti
Codice insegnamento 98369
Ricevimento Laura Gaggero: Su appuntamento da concordare con il docente, via telefono, email, aulaweb.
Corsi di laurea, sedi, programma, obiettivi, modalità d'esame e altre informazioni
- Docente: Laura Gaggero
Codice insegnamento 61722
Ricevimento Pietro Marescotti: Il docente è reperibile scrivendo a pietro.marescotti@unige.it
Inizio lezioni: Consultare orario dettagliato al seguente link: https://easyacademy.unige.it/portalestudenti/
Corsi di laurea, sedi, programma, obiettivi, modalità d'esame e altre informazioni
- Docente: Nicola Campomenosi
- Docente: Pietro Marescotti
Codice insegnamento 61724
Inizio lezioni: Consultare orario dettagliato ai seguenti link:
https://easyacademy.unige.it/portalestudenti/
https://corsi.unige.it/corsi/9009/studenti-orario
Corsi di laurea, sedi, programma, obiettivi, modalità d'esame e altre informazioni
- Docente: Paolo Antonino Maria Triolo
- Docente: Stefano Vassallo